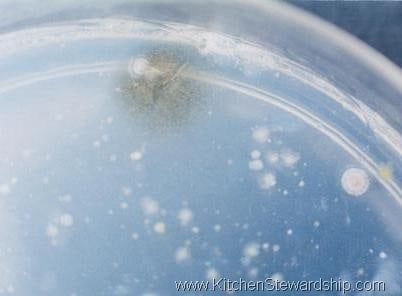
antibacterial hand soap experiment

- The Antibacterial Hand Soap Research Project
- What Happened to Triclosan?
- What is Triclosan?
- How Triclosan is Harmful
- Why Triclosan is Bad
- FDA Antibacterial Soap Ban
- Antibiotic Resistance: The Biology
- Get the Antibacterial Hand Soap and Cleaners Out
- My Favorite "Anti-Antibacterial" Recommendations
- Have You Tried Silver?
I’ve been passionate about healthy, non-toxic soap for YEARS. It’s so important to use regular soap vs. non-antibacterial soap. Remember Triclosan, the active ingredient in antibacterial soap? Well it was banned from soap in 2016, but that’s not the end of the story on antibacterial products!1,2

Triclosan may have been banned from soaps, but something is replacing it as the active ingredient in antibacterial products. Is antibacterial soap even more effective than normal soap or can we just use regular old soap to avoid the potential dangers of antibacterial hand soap?
I’m afraid it may be a BPA situation. Everyone jumped on the BPA free plastic bandwagon and now we’re hearing that the replacements like BPS and BPF are just as bad or worse. sigh (That’s one reason why it’s a good idea to reduce plastics overall!)
My bottom line: we’re still better off avoiding antibacterial soaps.
Let’s dig in!
The Antibacterial Hand Soap Research Project
I’m passionate about hand soap. Most of my closest friends don’t even know this about me, but it’s been a part of my life for a long time. (My husband is aware of this relationship, by the way. 😉 )
After conducting my own research in college (see below), I became convinced that antibacterial hand soaps are nothing more than a marketing technique created to exploit consumers’ fears about cleanliness and our general germaphobia.
They don’t do anything beneficial, and their naughty side effects are about to alarm you if I do my job properly. The benefits do not outweigh the dangers of antibacterial soap.
Since college, I’ve gradually changed the way my family purchases and uses hand soap and other cleaners. The more I learn, the more I filter out, and over time I’ve switched to buying natural and organic options for nearly all my family’s body care products.
My degree is not in science – not by a long shot – but I’m definitely a science-minded geek, which is why I much preferred teaching elementary school so I could dabble in all subjects in spite of my English degree.
I was blessed to take an incredible course teaching teachers basic science and all the skills necessary to “be scientists,” and my independent research project fueled the fire of my soapy passion.
I was curious about all the “antibacterial” hype and whether or not antibacterial soap actually performed any better than its traditional counterpart. Who else would get geeked about this project?
- designing an experiment to test the effectiveness of various soaps
- purchasing antibacterial and standard versions of bar and liquid soaps
- making petri dish gel (seriously cool stuff!!)
- researching how triclosan works (this was obviously before the ban, but it’s still important to know!)

The Science of Washing Your Hands
First, let’s explore what happens when you wash your hands.
Let’s start with water: water has a cohesive property. It likes to “stick” to itself. This explains why water forms droplets, why those water strider insects can walk on water and why water creates a meniscus (the curved shape of the top of the water when you look at it from the side, as if in a measuring glass).
Water also has an adhesive property: it will “stick” to other objects. Just drip water on a vertical surface, like your shower wall, and you’ll see this in action. Droplets stay together as droplets (cohesion), and the water stays on the wall (adhesion).
Water will naturally adhere to the dirt on your hands and wash it away.
Now enter soap: Soap’s job is to get water to increase its adhesive property. Most soap contains “surfactants”, a short word for “surface active agents” which do what they say they’ll do: act on the surface tension of the water. It does this by breaking the cohesion and thereby reducing the surface tension of the water.
We all know oil and water don’t mix. That’s because oil is made up of molecules that are hydrophobic, meaning not that they have a Psycho-style fear of (shower) water, but that they are repelled by water.
Surfactants have two different ends, one of which is hydrophobic and the other is hydrophilic, which means it attracts water.
Like objects attract: the hydrophobic end of the soap attracts the hydrophobic oil molecules, while the hydrophilic end of the soap grabs the water. This allows not only your standard-issue dirt to be washed away down the drain, but also your grime and oily gunk, too, with soap acting as the middle man. The one drawback is that soap also washes away your skin’s natural oils, which explains why our hands tend to get so dry after frequent handwashing.
Ultimately, we don’t necessarily care if the bad bacteria lives or dies: we just want it away from our food and our family, running down the pipes to the water treatment plant…where they will then kill the bad guys, I suppose.
The Method I Used For My Antibacterial Soap Experiment:
- I touched all sorts of nasty things in my college dorm’s community bathroom, the same things every time. You know that was disgusting and germ-filled!
- I washed my hands with warm water and rubbed hard for 30 seconds and dried with the blow dryer.
- I swiped my fingers onto a clean petri dish for each test and labeled what kind of soap I used.
- I waited for bacteria, mold, and fungus to grow in my dorm room. Yes, my poor roommate often references this in her “why I didn’t live with Katie senior year” monologue along with other strange and exotic science experiments I had going that semester. (She’s still my best friend, in spite of the bacteria and even the overflowing bean fiasco!)
- Tests included:
- the reference sample without washing
- washing with only water
- waterless hand sanitizer
- 2 Lever 2000 bar soaps: antibacterial and original
- Dial antibacterial liquid
- Dial antibacterial bar
- 2 Softsoap liquids: antibacterial and “moisturizing”
I realize that most people don’t wash their hands for a whole 30 seconds, but that is the recommendation for hand-washing. It’s really quite a long time when you’re counting it out for real! I should have done all the tests with a 7-second handwash, which is about what I probably accomplish on average with the life of a mommy.
The Result: Regular Soap vs. Antibacterial Soap

This is a portion of the petri dish before washing my hands (the most disgusting section, of course): About 25% of the total dish was covered in growing things.
After washing with soap, five of the petri dishes had something growing in them. However, all five had only eight or fewer deposits, most measuring 1mm or less with the largest spot at 2.5 mm. Most of the bacteria, fungus, and mold either died or went down the drain, which is all the same to me and my health.
Only Dial antibacterial soap showed no measurable growth. The worst of the six was Softsoap antibacterial liquid, but again let me reiterate that all six did a remarkable job reducing the bacterial growth on the petri dishes.
I concluded that antibacterial soaps are no better than regular soap at cleaning one’s hands.
Although my hypothesis was generally proven true already, I stumbled across some little nuggets that really got me thinking, including:
- How well water alone worked.
- What else was still on my hands after a good wash.
- How poorly waterless sanitizer worked.
Water Alone
A good scrubbing with no soap whatsoever resulted in only twice as many spots as the worst-performing soap. Yes, some of them were larger, so there were probably four times as many bacteria and other growing things, but I was very impressed that water alone could make such a dent.
I maintain to this day that it is the scrubbing and the water that are the keys to good handwashing and that soap is only a lowly assistant that improves the already efficient process. Here’s the photo of water alone: This is the worst part of the dish, just as with the photo above. It simply doesn’t look that intimidating to me! What do you think?
This is the worst part of the dish, just as with the photo above. It simply doesn’t look that intimidating to me! What do you think?
A Good Scrubbing Will Get You…
…Soap still on your hands. I noted in my report that I continued to make soap suds with my vigorous rubbing while drying my hands under the blow dryer. This is after 10 seconds of scrubbing soap onto my hands and 20 full seconds of scrubbing soap off under running warm water.
Frustrated, I ran a test with no petri dish with a full minute of handwashing, rubbing as hard and fast as I could under running water. Still, a soapy film announced itself under the blow dryer. It made me wonder how much soap we walk around with on our hands (and consequently eat, especially for the under-five set in our homes).
What About Alcohol-based Sanitizers?
It’s important to note here that I’m not against alcohol-based sanitizers. I think they have their place, and because the active ingredient is alcohol, not antibiotics, they don’t participate in germ warfare and bacterial resistance in quite as damaging a way as antibacterial soaps.
RELATED: Best Natural Hand Sanitizers Reviewed
On the other hand, sometimes I think about this picture when I rely on waterless hand sanitizer:
My skin crawls just looking at that fuzziness. This petri dish cultured after using a nickel-sized dollop of Purell instant hand sanitizer. I don’t think I ever use that much hand sanitizer after a diaper change on the go, so my hands probably aren’t even getting this clean! There was barely a difference between the “before washing” petri dish and the sanitizer version. Good thing a little dirt (and bacteria) is good for our immune systems!
Does Soap Kill Germs?
Basically, my results echo other published research that proves that antibacterial soap doesn’t get your hands significantly cleaner than regular soap. Plain water and good scrubbing actually resulted in a Petri dish that was pretty doggone similar to all the others, anti-bac and regular soap included. I was pleasantly surprised.
So use soap. Use plenty of water. And rub those hands together to get the dirt and germs dislodged and ready to be washed away by the magical powers of adhesion and surfactants! “Antibacterial” chemicals are unnecessary, ineffective, and harmful to the overall environment we call Earth.
I tell my kids that soap, water, AND friction are on a team. Water is the most valuable player, then the rubbing, then the soap as the assistant coach. Your real goal in washing your hands is to get the germs and dirt OFF your hands and down the drain.
Note: Of course my research was not replicated, peer-reviewed, or official in any way. Please be sure to read other sources as well and make your own decision based on real science. Science at the time in the early 2000s echoed my findings, but the landscape may have changed quite a bit since then. I’m still fervently personally against antibacterial soap, also considering that when we wash our hands, we want to also kill/remove viruses and fungi, so it’s really not necessary to kill all the bacteria, just get it down the drain.
What Happened to Triclosan?
Since it has been banned in 2016, triclosan isn’t a prevalent hazard anymore. Even though the ban was only on triclosan in soaps, it appears as though triclosan has been removed from most other places as well. (Hopefully, because companies noticed that people didn’t want it in their deodorant and toothpaste anymore!)
In searching for products still containing triclosan the easiest place to find it was non-consumables. If you see the word “microban” on cutting boards, clothing, or cleaning clothes, that contains triclosan.
This is the kind of story that causes us to be skeptical when the FDA approves something. It’s awful that antibiotics are in the waterways and the rest of our environment. We can’t undo the damage to the earth.
What if the new antibacterial chemicals being used in soaps are just as bad?
If you’re interested in the health and environmental impacts of triclosan, here’s an excerpt from a post I wrote about it before the ban:
[purplebox]
What is Triclosan?
Triclosan [was] the chemical added to antibacterial soaps (or triclocarbon for hard products like bar soaps) with the aim of killing bacteria.
It is non-discriminatory in that it won’t only kill the bacteria you’re mad at, but also any good bacteria you have hanging around your house (or inside your body). It is a specialized killer, however, in that its effectiveness lies in coaxing bacteria not to reproduce.
Learn to associate this word with, “No way! I won’t buy that!”
As of 2001, 76% of liquid soaps and 29% of bar soaps sold for household use is antibacterial (even that seems like a low estimate to me based on what I see in my world).3 Absolutely NONE of it needs to be.
How Triclosan is Harmful
Because of the handful of bacteria that manage to survive their encounter with triclosan, it contributes to what is commonly known as “bacterial resistance”, which basically means that the more we fight bacteria, the more the bacteria who can survive reproduce and the stronger the bacteria pool becomes.4
The bacteria who are naturally selected to continue their gene pool will result in (more and more) overall resistance to triclosan, and possibly other antibiotics, especially those that work in the same way, creating the “super-bugs” no one wants to come home with after touching a shopping cart handle.
Every time you wash your hands/dishes/etc with a soap containing triclosan, you’re sending unknown amounts of the chemical into our collective ecosystem, and bacteria becoming stronger against us, the human race.
RELATED: Natural Disinfectant Alternatives to Bleach.
Why Triclosan is Bad
- It’s an endocrine and hormone disruptor5
- It creates chloroform (link removed)when mixed with chlorinated water. (Almost all city water is chlorinated, and washing your dishes is an ideal environment for you to inhale toxic chloroform: hot water, chlorine, and antibacterial soap containing triclosan)
- It absorbs into your skin and mucous lining after washing6
- It is not completely removed by wastewater treatment processes, so it ends up in both our lakes and drinking water. As a result, it has been found in human breastmilk, and its toxicity to aquatic life puts our lake and stream ecosystems in grave danger7
If I Haven’t Convinced you Yet!
- Effectiveness: Triclosan must be left on a surface for 2 minutes in order to work properly. Who washes their hands that long? It’s killing bacteria everywhere else once it’s washed down the drain, but not on our hands.
- Limitations: Most diseases that we’re worried about catching are viral, anyway, and triclosan doesn’t touch viruses.
- Side Effects: Even the bacteria that we’re afraid of (E. coli is one example) are only getting stronger because of our overuse of triclosan.
[/purplebox]
FDA Antibacterial Soap Ban
Before the FDA came to a conclusion, they even agreed that triclosan isn’t proven to be more effective than just soap and water. (Sound familiar? Turns out my college experiment was on track!)
What I don’t understand is, if studies found that regular soap was just as effective as antibacterial soap, why do companies continue making antibacterial soap?
If it probably doesn’t do anything special, why bother with it? I’m reaffirmed in my decision to get the antibiotic hand soap and other antibiotic products out of my house and keep it out.
Effectiveness aside, there’s another reason to remove antibacterial products: antibacterial resistance. Benzalkonium Chloride is the most common replacement for triclosan in antibacterial soaps, and it’s been linked to antibacterial resistance.8
[yellowbox]
Antibiotic Resistance: The Biology
Here is some interesting information about antibiotic resistance from a blog colleague who used to blog anonymously as SnoWhite of Finding Joy in My Kitchen—and she’s also a PhD plant biologist!
How does our use of antibacterial soaps contribute to super-bugs?
1) Not all bacteria are genetically identical. Even though on the surface bacteria (for example, E. coli) seem identical, there is a lot of variation in the population. Some E. coli bacteria have different genes than others. Some have a gene that makes them resistant to antibiotics, some don’t.
2) The bacteria’s environment matters. When E. coli bacteria are not exposed to antibiotics, these genetic differences in their resistance to antibiotics really does not matter. In this environment, all bacteria have a similar chance of surviving and reproducing offspring (read: our normal hand soap is an equal opportunity bacteria killer). However, when E. coli are exposed to an antibiotic, say triclosan in our hand soap, the variation in the population of E. coli creates a difference.
3) The result: A “Super Bug” Population of Bacteria. Antibiotic resistant bacteria are often termed “super bugs” because they are unable to be killed off by our antibiotics. This “super bug” population of bacteria is now resistant to triclosan, because all the bacteria that were not resistant were killed off and unable to reproduce.
In both Case #1 and Case #2 above, it is important to realize that bacteria are not learning to fight back. Just like you and I have no control over our genetic make-up, bacteria cannot change their genetic make-up in response to a change in their environment. Bacteria reproduce so quickly that those without the gene for resistance die and the non-resistant gene quickly disappears from the population and the result is what appears to be a population of bacteria that are fighting back against our antibiotics.
By cutting down on our antibacterial soap use, we can help prevent these changes in the bacterial population. When we stop using soaps with triclosan, we are no longer just killing bacteria that can be killed by the antibiotic, we have an equal chance of killing any bacteria in the population! This helps because bacteria without the resistance gene can remain in the population and reproduce offspring so that this gene remains in the population.
[/yellowbox]
Get the Antibacterial Hand Soap and Cleaners Out
Phew! Now that we’ve gotten through all that, it’s time to take action! Protect your family and the environment by getting problematic antibacterial soaps and other products out!
Evaluate the Antibiotic Products in Your House
Take a walk around your house, or just read a bottle or two as you brush your teeth or do dishes.
The antibacterial agent is most often listed as the “active ingredient” separate from the long list, but I’ve found it hiding near the end of the ingredients list on some sanitizers. Common antibacterials to look out for are “triclocarban, benzalkonium chloride, benzethonium chloride, chloroxylenol, and chlorhexidine.“9
While you’re at it, check to be sure you don’t have any holdover triclosan way in the back of the cleaning cabinet.
The Environmental Working Group notes to look out for the following phrases on everyday objects like toothbrushes and toys: “antibacterial,” “fights germs,” “protection against mold,” “odor-fighting” or “keeps food fresher, longer.”
Be wary of “microban” which is another way to say antibacterial properties in nonliquid products as well.
Bonus points: Start making a list so that when you find antibiotic products you can make a note to search for an alternative. Once you’re ready to make some changes, move on to step 2.

Switch Slowly as You Use up Your Antibacterial Products
If you found a bunch of antibiotic-containing products you may be wincing at the idea of throwing it out and wasting all that money.
Besides, the antibiotics will still get into the environment whether you use it or toss it.
Here are my doing-your-best solutions to avoid waste and reduce exposure to toxins in antibacterial soaps and other items as you prioritize which items to switch first.
Soap and Hand Sanitizer:
When I first switched to regular soap, I had two bottles of antibacterial soap left that I kept under the sink. I’d use them after touching raw chicken or eggs or when someone in the house was sick.
I did NOT buy antibacterial soap for this purpose, and when it ran out I didn’t replace it.
Save non-alcohol based hand sanitizer for instances when you really can’t access soap and water. I’ve seen people use it instead of soap and water whenever they wash their hands. (See above petri dish image and shudder!)
RELATED: More about the safety of hand sanitizers
Both of these strategies will reduce your daily exposure to the antibiotics, but allow you to use up what you have.
Toothpaste, Mouthwash, and Antiperspirant:
Your mouth needs its happy bacteria for good digestion and to prevent cavities! Toothpaste and mouthwash are top on the list of things to switch. I don’t think the health risk is worth using up what you have.
If possible switch these out right away or when you finish up your open container. (Do not swallow either of these products and maybe switch out the kid’s toothpaste first if the budget is tight!) If you have unopened toothpaste give it away or toss it.
We like OraWellness and EarthPaste for teeth.
Interesting tip: You can spray mouthwash on plants fighting blight or fungus.
Antiperspirants have a host of health problems aside from antibiotics. I’ve had great results with my homemade deodorant.
Dishtowels, Washcloths, and Sponges:

Throw them out as they wear out and you need new ones.
I’m fortunate not to have any of these on hand, but I think they’re gaining in popularity with most unknowing consumers! Use these reusable and biodegradable sponge cloths instead.
Cutting Boards:
Designate other boards for your daily use and this as a backup…or a wall ornament!
Cleaning Products:
Cleaners are an area where you probably do want some antibacterial options. Thankfully, this one can be pretty simple to switch out because you can make your own cleaners that are quite effective and frugal.
I use three simple products to clean just about everything in my house, and here’s an easy chart of all green cleaning alternatives featured at KS. Keep in mind, the CDC has admitted that there are natural alternatives that are just as effective as bleach.
If you have unused cleaning supplies to get rid of you can Freecycle or donate instead of throwing them away.
My Favorite “Anti-Antibacterial” Recommendations
Just buy regular SOAP.

$$$Big time money saver$$$: Buy a huge jug refill of normal soap and use a foaming pump, like we did here for homemade baby wash.
Added bonus: You’ll save the earth, too, because you use less plastic this way.
[redbox]
To refill foaming pump with regular liquid soap:
- Fill bottle about 2/3 of the way with water (I always use warm or hot, but I don’t know if it makes or breaks the deal).
- Then top off the last 1/3 with liquid soap.
- Use your hand to cover the top and shake to combine–be ready for bubbles!
- Then insert the pump, and you’re good to go.
Beware of putting the straw-like end of the pump directly into liquid soap; if even a teeny bit gets pulled into the straw, you’re doomed. Your foamy pump will never recover. That’s why you must shake first! [/redbox]
I prefer to use Truly Free liquid soap concentrate in my foaming pumps with water. It’s a concentrated solution, so you don’t need much. It feels like conventional soap on your hands, which may be a perk if you’re switching from grocery-store soaps.
[redbox]
Pssst, quick note that Truly Free’s best deal right now is for the laundry room: get 100 loads of laundry free, plus their whole stain removal system, including their oxygen bleach, stain stick, washing machine cleaner, and a dryer angel to make your clothes smell amazing! All non-toxic products we adore.
[/redbox]
A friend of mine told me she buys foamy pumps with antibacterial soap and then dumps the liquid down the drain and refills with good stuff – I nearly died of shock! I begged her to stop – we can’t try to save our families at the expense of our world. We are an indivisible part of the world, and we don’t want ANY antibiotics floating around if we can help it.
You can buy empty foaming hand soap bottles or buy foaming soap without antibiotics and then refill when it’s empty.
Good old bar soap works great and is soooo much more frugal than the pumps. Here are my favs:
- MadeOn
- Earthley Charcoal Facial Bar, 3-in-1 Soap Bar, & Shampoo Bar
- Bend Soap (use the promo code KS10 for 10% off entire order)
- Dr. Bronner’s
Many antibacterial cleaners and hand sanitizers have substituted alcohol as their active ingredient. While it might be more drying to your skin, alcohol doesn’t contribute to antibiotic resistance.
[question]Are you ready to kick the antibacterial soap to the curb? What steps will you take to get the antibacterials out of your home?[/question]
Other posts to help you avoid antibacterial products:
- Are Hand Sanitizers Safe or Do They Create Superbugs?
- Review: Best Natural Hand Sanitizer
- Clean with Green from Floor to Ceiling
- Green and Natural Body Products
[redbox]
Have You Tried Silver?
Silver nanoparticles have been shown in studies to “be active against several types of viruses.”
3rd Rock’s Silver Excelsior Serum and Silver Infusion Tonic has their patented Chelated Silver Oxide. It’s different and unique in the silver world compared to common, run-of-the-mill ‘colloidal silver’ (source).
This silver is high quality with many health-benefits. Containing amino acids, citrates, and kosher vegetable USP grade glycerin, 3rd Rock silver sticks to and penetrates cell walls—delivering silver oxide straight to cells to bolster their fight against infections in and on the body.
[/redbox]
Find safe products for personal health at EWG’s Skin Deep database.
Sources
- Antibacterial Soap? You Can Skip It, Use Plain Soap and Water. (2019, May 16). Retrieved from http://www.fda.gov/consumers/consumer-updates/antibacterial-soap-you-can-skip-it-use-plain-soap-and-water
- FDA issues final rule on safety and effectiveness of antibacterial soaps. (2016, September 2). Retrieved from http://www.fda.gov/news-events/press-announcements/fda-issues-final-rule-safety-and-effectiveness-antibacterial-soaps
- Perencevich, E., Wong, M., & Harris, A. (2001). National and regional assessment of the antibacterial soap market: A step toward determining the impact of prevalent antibacterial soaps. American Journal of Infection Control, 29(5), 281–283. Rrtrieved from www.ncbi.nlm.nih.gov/pubmed/11584251.
- Safety and Effectiveness of Consumer Antiseptics; Topical Antimicrobial Drug Products for Over-the-Counter Human Use. (2016, September 6). Retrieved from http://www.federalregister.gov/documents/2016/09/06/2016-21337/safety-and-effectiveness-of-consumer-antiseptics-topical-antimicrobial-drug-products-for
- Guo, J., Wu, C., Zhang, J., Xiao, H., Lv, S., Lu, D., … Zhou, Z. (2020). Early life triclosan exposure and neurodevelopment of children at 3 years in a prospective birth cohort. International Journal of Hygiene and Environmental Health, 224, 113427. Retrieved from https://www.ncbi.nlm.nih.gov/pmc/articles/PMC5924494/
- Weatherly, L. M., & Gosse, J. A. (2017). Triclosan exposure, transformation, and human health effects. Journal of Toxicology and Environmental Health, Part B, 20(8), 447–469. Retrieved from https://www.ncbi.nlm.nih.gov/pmc/articles/PMC6126357/
- Bever, C. S., Rand, A. A., Nording, M., Taft, D., Kalanetra, K. M., Mills, D. A., … Hammock, B. D. (2018). Effects of triclosan in breast milk on the infant fecal microbiome. Chemosphere, 203, 467–473. Retrieved from https://www.ncbi.nlm.nih.gov/pmc/articles/PMC6126357/
- Merchel Piovesan Pereira, B., & Tagkopoulos, I. (2019). Benzalkonium Chlorides: Uses, Regulatory Status, and Microbial Resistance. Applied and environmental microbiology, 85(13), e00377-19. Retrieved from https://www.ncbi.nlm.nih.gov/pmc/articles/PMC6581159/
- Rundle, C. W., Hu, S., Presley, C. L., & Dunnick, C. A. (2019). Triclosan and Its Alternatives in Antibacterial Soaps. Dermatitis, 30(6), 352–357. Retrieved from https://pubmed.ncbi.nlm.nih.gov/31688130/





Oh, yes I do have colloidal silver. I used to purchase Sovereign Silver from Amazon, but recently I bought a silver generator and now make my own! Yes, it is safe, and yes, it WORKS! I RARELY take it internally, but if you are careful and use a trusted source it can be helpful. Recently, I used it for a tooth that had the filling fall out of the middle, leaving a deep hole in the tooth. I took Sovereign Silver, neat, added 1 drop of tea tree Essential oil and 2 drops of Oregano essential oil, in a large glass of the SS. ( I do NOT ingest, it is spit out) and swished hard and ‘pulled’ it a bit over the tooth for several minutes. I could feel the pain leaving and the facial area pain around it diminished as well. I do this several times a day, usually after eating and brushing. It has helped a lot. I do plan to have the tooth pulled, but for now, this is working.
So, I do plan to add some colloidal silver to my cleaning products (homemade) at the time of use. Great idea!
We’re so glad that worked for you! Thanks for sharing!
I haven’t used antibacterial soaps for a very long time. Every so often, when I feel like my dishes or cook-wear has been ‘contaminated’, I’ll put a few drops of my homemade 4 thieves oil in the water or dishwasher. I also use a few drops in every laundry load, because I have a permanent case of candida due to diabetes and the meds I take.
Also, my cleaning rags are purchased organic cotton cloths or old washcloths repurposed for dishes and cleaning. The dishcloths and hand towels are switched out DAILY for new ones, and when laundered, the 4 thieves drops are used. Towels are switched out weekly, same procedure.
It is important to be clean, however, being TOO clean is NOT healthy!
It’s great that you’ve found a solution that works for you!
Another thing you will notice when giving up antibacterial soap is….Your drains will stop smelling! Just like living things, drains need a balance of bacteria flora too.
Great article and Thank you for your thoughts, the research, and the great information. As a researcher with a Biomedical degree, and a Chemistry minor, and an autoimmune disease , where I have to be careful with situations as viruses and bacteria, I encouraged my son to do a project to determine ” Do Antibacterial Soaps Really Work?” This project won the State Science Fair in Texas. Without a doubt, the results showed that antibacterial Soaps did a significant better job in diminishing the occurrence of cultures in the petri dishes, which were bought from a professional science lab, and professionally prepared. There are reasons we publish research that is replicable before sharing it with a community that might take the information as science. Perhaps a more thoughtful approach would be to share that each person takes the responsibility for their own choices, and that is to include the choice whether to use an antibacterial soap. One prayer is that the plastic we do use are made healthier. I appreciate your kindness in allowing me to share, and Thank you for trying to make our world a safer place.
Thank you for this note, Lisa, and congratulations to your son on an excellent science fair project! I agree that I’ll add a note to my conclusion that my “research” was just a project, certainly not replicated or peer-reviewed. Research at the time was echoing my findings, but it may be changing now.
Out of curiosity, how long did you son wash his hands with the antibacterial soap when the petri dish demonstrated higher effectiveness? I’m still of the opinion that it’s better to wash the bacteria OFF the hands than to try to kill it all, especially for our immune systems, which need a little hormesis regularly anyway.
Best, Katie